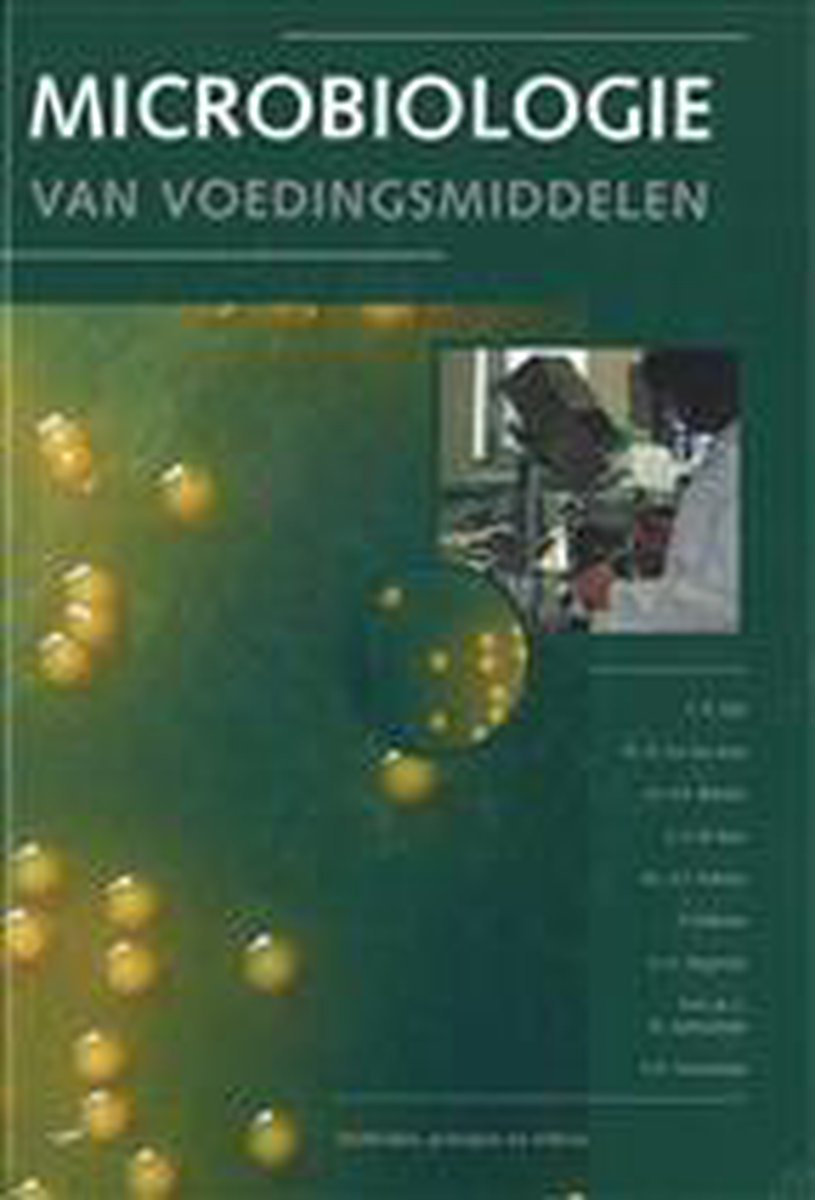
Microbiologie van voedingsmiddelen

Proeven van succes
sensorisch onderzoek: technieken, procedures en toepassingen
Maak tweedehands je eerste keus
- Let op: door stakingen bij BPost in België kan je pakketje later komen.
- 30 dagen retourgarantie
- Gratis verzending vanaf 4 boeken of 40 euro
- Krijg van 21 tot en met 29 juni 10%, 15% of 25% korting per stapel.
- Van 21 tot en met 29 juni 4=3 actie op alles.
ISBN
9789081923309
Bindwijze
Hardcover
Taal
Nederlands
, Overig
Auteur
Uitgeverij
Clou, For Marketing, Inform. En Research
Jaar van uitgifte
2012
Waar gaat het over?
Lees verder
Spijtig genoeg zijn er geen recensies over dit boek
Meer in Educatieve uitgaven

Pakket Keuzedeel Expressief talent deel A / Keuzedelen
nog 1 op voorraad
15,40

StruX - Nederlands; Spreken en gesprekken voor 1F Voor 1F; Deel 2 van 5
30% korting
nog 1 op voorraad
5,10
3,57

Nederlands / Luisteren; Voor 1F; Deel 1 van 2 / StruX
nog 1 op voorraad
14,40

Ik en de maatschappij / Democratie / StruX
nog 1 op voorraad
13,40

LEZEN IN BEELD LESBOEK E
30% korting
nog 1 op voorraad
6,90
4,83

Uittreksel Kritisch denken binnen het verpleegkundig proces
nog 1 op voorraad
13,40